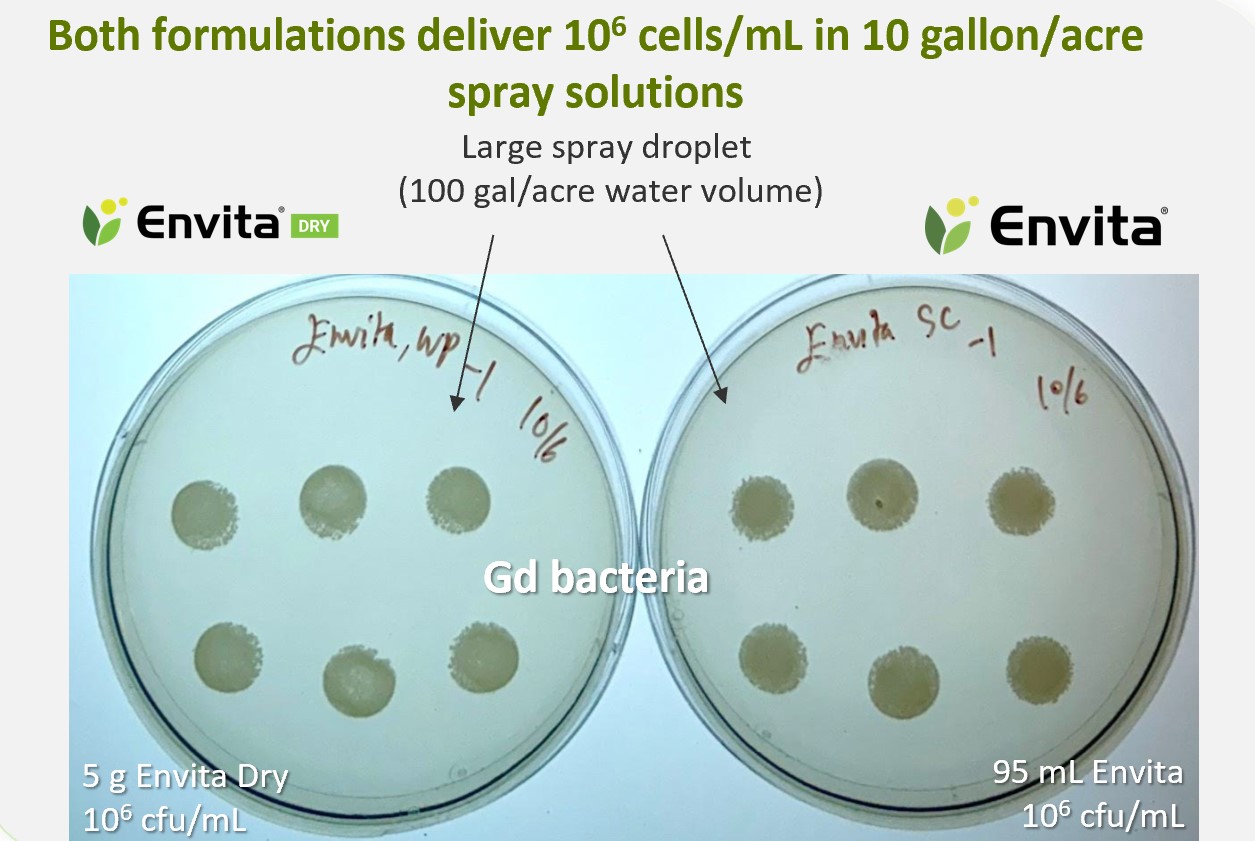
Comparing Envita Dry and Envita formulations

Is nitrogen use limiting your potato crop?
October 1, 2025
What is Envita Dry?
Envita® Dry is the leading nitrogen-fixing biological that lets you stay one step ahead of your plant’s nitrogen needs by enabling nitrogen fixation to occur in the plant’s leaves. Envita is systemic, ensuring this essential nutrient is available in the right place and at the right time, all season long.
Available exclusively from Syngenta in Canada, Envita Dry features the living bacteria Gluconacetobacter diazotrophicus – a naturally occurring food-grade bacteria that enables a unique mode of nitrogen fixation in a wide variety of crops.
After application, the bacteria form a symbiotic relationship with the host plant, ultimately replicating and spreading through the plant’s cells. The bacteria then begin fixing nitrogen from the air and continue to do so throughout the season, offering the host plant an alternate source of nitrogen from application through harvest.
Trial results
From 2022 to 2024, Syngenta partnered with growers across Canada to trial Envita nitrogen-fixing biological in potatoes, in both the liquid and dry formulation, adding it to their existing fertilizer, irrigation and pest management programs, keeping the rest of their program unchanged.
Envita Dry is equivalent to the previous Envita liquid formulation, having the same active ingredient with the same load and performance.
In trials where both formulations were compared, there was no significant difference in performance.
▄ Envita
▄ Envita Dry
The result: 83 per cent of the trials showed a positive yield response from one application of Envita or Envita Dry, with an average yield improvement of 32 cwt/acre when compared to the untreated check2.*
*Yield response and average yield improvement figures determined by combining yield data from crops treated with Envita liquid together with yield data from crops treated with Envita Dry.
Maximize your Envita Dry application with these tips:
Apply either first thing in the morning when stomata are open but before drying time is accelerated, or later in the afternoon after the heat of the day has passed. Avoid evening applications when the stomata are closed.
Envita Dry is best applied solo, with a non-ionic surfactant at 0.1% v/v.
- Should you take a decision to tank mix Envita Dry, be aware of the following: Until a tank mix partner is formally tested in Canada by the manufacturer (Azotic), growers should assume that any tank mix partner may have an adverse effect on Gluconacetobacter diazotrophicus (“Gd”, the active ingredient in Envita Dry). Testing to date has shown that some formulations, including some formulations of glyphosate, are harmful to Gd in the mix after one hour.
- If you do take a decision to tank-mix Envita Dry, follow the best management practices recommended by Azotic:
- Store Envita Dry in a cool, dry place.
- Envita Dry is best applied alone, with a non-ionic surfactant.
- If putting in a tank mix, please follow the Tank Mix Partner Guidelines from Azotic (the manufacturer), and be sure to put Envita Dry last in the tank;
- Use high volumes of water. Minimum water volume of 10-15 gal/ac.
- Optimal application temperatures:
- Above 80% relative humidity: 10-30ºC
- Below 80% relative humidity: 10-25ºC
- When relative humidity is above 80%, apply between 10-30ºC. When relative humidity is below 80%, apply between 10-25ºC.
Not all products can be tank mixed with Envita Dry. For compatibility information, visit: https://www.syngenta.ca/productsdetail/envita-dry#tank-mix.
Key takeaway
The team at Syngenta continues to run grower trials each year, building on our experience and agronomic insight into biologicals. To date growers have used Envita Dry in addition to their standard fertilizer program, letting it fill the crop’s nitrogen needs throughout the growing season when standard fertilizer may not be available.
Looking for more information or wondering about how Envita performs in other horticulture crops? Talk to your local Syngenta rep or retail partner.
1 Photo source: Third party testing of Envita cell counts at 10 gallons an acre water volume (n=1). Figure source: Grower conducted trials (n=12) in 2023 and 2024 where both liquid and dry formulations of Envita were assessed in the same field. Canola (n=2), corn (n=2), potatoes (n=3, spring wheat (n=3), (winter wheat (n=2), white beans (n=1), soybeans (n=2) ).Performance evaluations are based on internal trials, field observations and/or public information. Data from multiple locations and years should be consulted whenever possible. Individual results may vary depending on local growing, soil and weather conditions. Always read and follow label directions. Trademarks are property of their respective owners.
2 Source: Grower trials conducted in AB, SK, MB, ON, QC, PE, in 2022-2024. Envita liquid (n= 58), Envita Dry (n= 2), both formulations (n=3). Gluconacetobacter diazotrophicus was applied at 95 mL/ac or 5 g/acre. Envita Dry delivers the same amount of active ingredient per hectare as Envita Liquid. Yield determined by 3x10 ft digs or distance to fill a truck at harvest. Yield response and average yield improvement figures were determined by combining yield data from crops treated with Envita liquid together with yield data from crops treated with Envita Dry*.
Performance evaluations are based on internal trials, field observations and/or public information. Data from multiple locations and years should be consulted whenever possible. Individual results may vary depending on local growing, soil and weather conditions.
Always read and follow label directions. The Syngenta logo is a trademark of a Syngenta Group Company. Envita® is a trademark of Azotic Technologies Limited. Used under license.